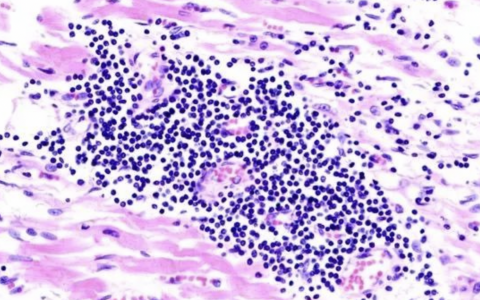
每日一题_2022.08.16

A 43-year-old woman with pulmonary arterial hypertension(PAH) due to scleroderma, diagnosed four years ago, currently stable on IV epoprostenol, oral sildenafil, and warfarin, presents with right upper quadrant pain. When her PAH was first diagnosed, she was New York Heart Association (NYHA) functional class (FC) IV. On therapy she has improved to NYHA FC II. She has been experiencing intermittent right upper quadrant (RUQ) pain that is exacerbated by eating a fatty meal. It worsened after she ate yesterday. Workup shows gallstones, with biliary ductal dilation and pericholecystic fluid on RUQ ultrasound. Laboratory data is notable for white blood cell count 14,200/ μL, total bilirubin 3.2 mg/dL, alkaline phosphatase 425 U/L, and INR 2.8. She is diagnosed with acute cholecystitis and is scheduled to undergo surgery later today.
Which of the following is the proper perioperative management of her PAH therapy?
A. Continue all her current treatments without change.
B. Reverse the warfarin and continue the epoprostenol and sildenafil.
C. Reverse the warfarin, hold the epoprostenol due to its platelet-inhibitory effect, and continue the sildenafil.
D. Reverse the warfarin, hold the epoprostenol due to its platelet-inhibitory effect, and hold the sildenafil due to risk of systemic hypotension.
答案解析:
由于对心输出量 (CO) 和肺血管阻力 (PVR) 的影响,右心无法耐受手术和插管带来的变化。 右心容易受到 PVR 增加的影响。 在手术过程中,应避免低氧血症、高碳酸血症和酸中毒,因为它们会导致 PVR 增加。 维持 CO 和避免使用心肌抑制剂也很重要。 尽管 PAH 患者在手术中存在问题,但仍可能需要手术。
在围手术期管理药物可能具有挑战性。 前列环素的一些作用是肺血管扩张、抑制血小板聚集和肺循环中的抗增殖作用。 美国目前批准了三种前列环素,每种都有不同的给药途径:依前列醇 (IV)、曲前列素(皮下、吸入和口服)和伊洛前列素(吸入)。
依前列醇是一种合成的前列环素,是第一种被批准用于治疗 PAH 的药物。 它的半衰期很短,只有 3 到 5 分钟,因此必须通过连续输注来给药。 在室温下不稳定,必须冷藏。 较新的版本使用不同 pH 值的缓冲液,该缓冲液在室温下具有更好的稳定性,因此不需要冷却。 由于其半衰期短,突然停药会导致严重的反跳性肺动脉高压,这可能是致命的。 尽管前列环素具有血小板抑制作用,但由于存在反跳性肺动脉高压的风险,不应因手术而停药。
Treprostinil 是一种前列环素类似物,最初被批准用于皮下给药。 它的半衰期较长,为 4 至 5 小时。 IV、吸入和口服版本已被批准。 伊洛前列素是一种半衰期短的前列环素类似物,每 2.5 至 3 小时通过雾化给药。
西地那非是一种 5 型磷酸二酯酶抑制剂 (PDE5-I),被批准用于治疗 PAH。它通过一氧化氮途径起作用。通过阻断 PDE5,抑制了环 GMP 的分解,导致血管舒张。在临床试验中,西地那非已被证明可以增加 PAH 患者的运动能力并改善血流动力学。在 PACES 研究中,与单用依前列醇相比,依前列醇和大剂量西地那非的组合显示出额外的益处。 IV 版本已获批准,可用于无法口服药物的患者。静脉内给药时,西地那非的剂量减半。
有回顾性数据表明华法林可能为 PAH 患者提供生存益处。建议在这些患者中使用华法林。在该患者中持有华法林是手术所必需的,并且可以安全地进行。由于计划在今天进行手术,因此需要逆转 INR。术后,可以使用以肝素为基础的治疗,直到可以安全地重新开始华法林。
正确答案:B
原创文章(本站视频密码:66668888),作者:xujunzju,如若转载,请注明出处:https://zyicu.cn/?p=13640

 微信扫一扫
微信扫一扫  支付宝扫一扫
支付宝扫一扫